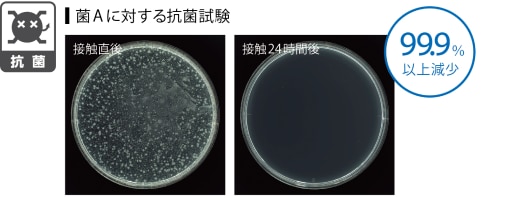

マティルNW W ソイルコンク
フロアタイル(塩ビタイル) - マティルNW W ソイルコンクの一覧|建材・住宅設備の通販ならミラタップ(旧サンワカンパニー)


土のような風合いをもった コンクリート調のフロアタイル
MATILW Soilconc
マティルNW W ソイルコンク
¥3,200 /m2
土のような風合いをもったコンクリート調の大判塩ビタイル。四面がラウンド加工された面取り仕上げで本物に近い、自然の風合いを表現しています。
ワックス不要のノーワックスメンテナンス仕様です。
特徴

防汚性 | 汚れが付きにくく落としやすい新UVコーティング

※試験方法(メーカー独自試験):床材表面に標準汚れ物質を乗せ、乾燥後不織布で水拭きし、汚れの除去具合を観察。
耐摩耗性 | ロングライフを実現する耐久性

※摩耗指数:JISA1451の試験を1000回転行った場合の摩耗量より、有効層がすべて摩耗するまでの回転数を求め、さらに床材の表面形状、材質の要因を加味して求めたもの。(エンボス品の場合はマイナス補正など)
抗菌性 | 衛生面でも安心感のある抗菌性能
※JIS Z 2801「抗菌加工製品・抗菌性試験方法・抗菌効果」に準拠
【試験期間】一般財団法人ニッセンケン品質評価センター(2025年実施)
薬機法の関係上、特定の菌名は表記しておりません。
カラーバリエーション

MAW-1137

MAW-1138

MAW-1139
-
- 品番
- VC05539
- マティルNW W ソイルコンク MAW-1137
- サイズ
- 609.6×609.6×t3mm
¥3,200/m2
- 発注単価
- ¥11,904/ケース
- 在庫
- 107ケース
- 納期
- 5~11営業日
-
- 品番
- VC05549
- マティルNW W ソイルコンク MAW-1138
- サイズ
- 609.6×609.6×t3mm
¥3,200/m2
- 発注単価
- ¥11,904/ケース
- 在庫
- 113ケース
- 納期
- 5~11営業日
-
- 品番
- VC05559
- マティルNW W ソイルコンク MAW-1139
- サイズ
- 609.6×609.6×t3mm
¥3,200/m2
- 発注単価
- ¥11,904/ケース
- 在庫
- 139ケース
- 納期
- 5~11営業日











